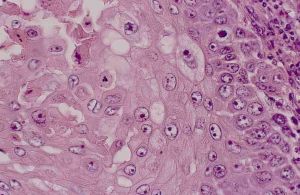
犬鱗狀上皮細胞癌

被復上皮
犬鱗狀上皮細胞癌
犬鱗狀上皮細胞癌被復上皮按細胞層數又分成單層上皮和復層上皮:
單層上皮包括單層扁平(鱗狀)上皮、單層立方上皮、單層柱狀上皮(有的有纖毛)、假復層柱狀上皮(有的有纖毛);復層上皮包括復層扁平(鱗狀)上皮、移行上皮。被復上皮有保護、吸收、分泌、排泄作用,可以防止外物損傷和病菌侵入。
單層上皮由單層細胞組成,常見於物質容易通過的地方。眼睛視網膜的色素層是單層立方上皮。分布在鼻腔、喉、氣管、支氣管等內腔表面的是假復層上皮。看起來像復層,實際是由不同高度的單層細胞所組成。較低的是杯狀細胞,它可以分泌黏液;較高的是纖毛細胞,它可以掃除被黏液層黏附的吸入的塵粒。
皮膚的表皮,口腔、咽食管、肛門和陰道的表面,還有眼睛的角膜是復層上皮。復層上皮由多層細胞組成,更有利於保護作用。
上皮常見的除了鱗狀上皮細胞,還有另外一種是腺上皮。
腺上皮
 鱗狀上皮細胞
鱗狀上皮細胞外分泌腺有胃腺、腸腺、汗腺等。它們是由腺上皮圍成的腺泡,分泌物流入其中央腔內,再由導管排到管腔或體表。
內分泌腺有腎上腺、垂體、甲狀腺、性腺等。腺細胞常排列成團狀、索狀或泡狀,沒有導管,激素分泌後立即進入毛細血管和淋巴管。
上皮組織再生能力很強,復層上皮的表淺細胞不時脫落,深部細胞不斷分裂增生,使上皮保持動態平衡。
健康檢查
表皮角化,腫瘤由鱗狀上皮細胞團塊所組成,不規則地向真皮內浸潤,棘細胞呈瘤性增生,呈條索狀或巢狀細胞團,邊緣以基底細胞層,中心部有角化性癌珠,在癌細胞團內有很多分裂象,周圍淋巴細胞和漿細胞浸潤。上皮組織實驗
單層上皮
單層扁平上皮:11號片,腸系膜裝片,硝酸銀鍍染。細胞質部分稍呈淡黃色,核呈空泡樣(如用染料復染,則可顯示出)。間皮細胞、內皮細胞之間的區別。單層柱狀上皮:13號切片,豬十二指腸橫切片,或膽囊切片。Bouin氏液固定,石蠟包埋,HE染色。小腸絨毛、柱狀細胞的胞核呈橢圓形、細胞的游離面紋狀緣、杯狀細胞、淋巴細胞。
假復層柱狀纖毛上皮:14號切片。豬氣管橫切片,Bouin氏液固定,石蠟包埋,HE染色。細胞核的排列高低不齊、柱狀細胞、纖毛、基細胞、杯狀細胞。
單層立方上皮:12號片腎小管或55號片甲狀腺切片,製片方法同上。立方形細胞,核為圓形,細胞界限清楚。
復層上皮
復層扁平上皮:65號切片,豬食管橫切片,Bouin氏液固定,石蠟切片,HE染色。矮柱狀細胞核為長橢圓形、多邊形細胞核為圓形或橢圓形、梭形或扁平細胞核深染固縮。
復層變移上皮:15號切片,動物膀胱橫切,Bouin氏液固定,石蠟切片,HE染色。空虛收縮狀態時上皮變厚,表層細胞呈立方形或橢圓形,體積較大;中層細胞為多邊形,基底層細胞多為矮柱狀或立方形。而當尿液蓄積膨脹時,變移上皮變薄,細胞形態也發生改變,表層細胞多呈扁平形。

